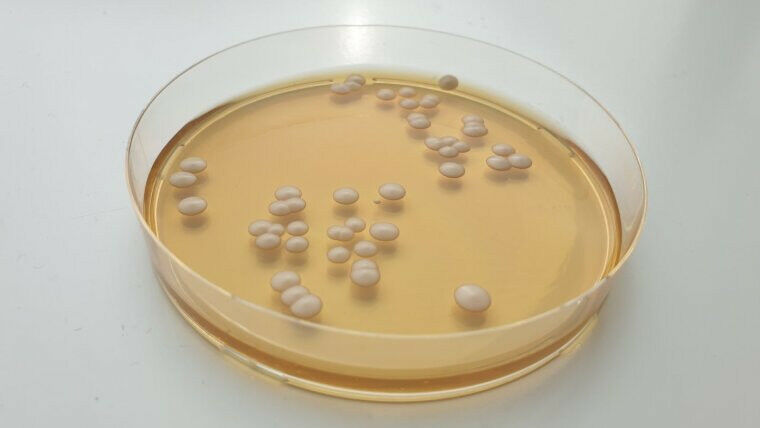
Kolonien von Candida parapsilosis. Foto: Grit Walther

Der Hefepilz "Candida parapsilosis" zeigt sich in Ein Team unter der Leitung von Amelia Barber vom Exzellenzcluster ,,Balance of the Microverse" der Friedrich-Schiller-Universität Jena und Grit Walther vom Nationalen Referenzzentrum für Invasive Pilzinfektionen (NRZMyk) untersuchten den Ausbruch eines multiresistenten, im Krankenhaus erworbenen Stammes dieses Pilzes. Dabei entwickelten die Forscherinnen und Forscher eine neue molekulare Nachweismethode, mit der sich verschiedene Stämme von "C. parapsilosis" schnell und kostengünstig differenzieren lassen. Die Ergebnisse wurden in "The Lancet Microbe" veröffentlicht.
Candida parapsilosis ist ein Hefepilz, der die Haut und den Verdauungstrakt von Menschen besiedeln kann und meist harmlos ist. Bei Menschen, deren Immunsystem durch eine Krebserkrankung oder eine Organtransplantation geschwächt ist oder die sich infolge einer schweren Erkrankung langen Krankenhausaufenthalten unterziehen müssen, kann es jedoch zu schweren Wundund Gewebeinfektionen bis hin zur lebensbedrohlichen Sepsis kommen.
So wie Antibiotika zur Behandlung von bakteriellen Infektionen eingesetzt werden, werden Antimykotika zur Behandlung von Pilzinfektionen verwendet. In den letzten Jahren hat jedoch die Häufigkeit von Stämmen, die gegen diese Medikamente resistent sind, dramatisch zugenommen, so dass diese Infektionen viel schwieriger zu behandeln sind.
Ein gefährlicher Pilz macht sich breit
Die Studie liefert eine detaillierte genomische Analyse eines langanhaltenden Infektionsereignisses, das durch antimikrobiell resistente C. parapsilosis in mehreren Gesundheitseinrichtungen in Berlin verursacht wurde. Das Forschungsteam fand heraus, dass ein einziger, genetisch nicht unterscheidbarer Stamm allein 33 invasive Infektionen zwischen 2018 und 2022 verursachte. Auch wenn sich die Zahl zunächst gering anhört, erfordern invasive Infektionen immer eine intensive medizinische Betreuung und führen zu einer starken Beeinträchtigung der Lebensqualität. Besonders besorgniserregend ist, dass sich der Erreger von Mensch zu Mensch und auch Über verschiedene Einrichtungen hinweg verbreitet. Seine Resistenz gegen die bevorzugten antimykotischen Medikamente macht ihn zu einer ernsthaften Bedrohung.
Bezeichnenderweise war der Stamm aus den Berliner Krankenhäusern eng mit Stämmen verwandt, die bereits in Kanada, im Nahen Osten und in Ostasien gefunden wurden, was die weltweite Ausbreitung arzneimittelresistenter Pilze belegt.
Entwicklung eines neuartigen Identifizierungsschemas
Die Forschenden haben in ihrer Studie nicht nur die genetischen Beziehungen und die Übertragungsdynamik der mit dem Ausbruch verbundenen Stämme von C. parapsilosis aufgedeckt, sondern auch eine neue Identifizierungsstrategie (Typisierung) für diesen Erreger entwickelt. Bei dieser als ,,Multilocus Sequence Typing" (MLST) bezeichneten Typisierungsstrategie werden mehrere kurze DNA-Regionen sequenziert, um Stämme genetisch zu unterscheiden. Dies bietet eine Alternative zur herkömmlichen Sequenzierung des gesamten Genoms.
,,Das neu entwickelte MLST-Schema ermöglicht eine schnelle und kostengünstige Unterscheidung und Verfolgung von C. parapsilosis-Stämmen. Damit können wir rasch auf neue Ausbrüche reagieren und so effektiv zur Eindämmung der Pilze beitragen. Das ist vor allem dann hilfreich, wenn eine Genomsequenzierung aus Kostengründen oder wegen fehlender Bioinformatikkenntnisse vor Ort einfach nicht möglich ist", erklärt Amelia Barber, Leiterin der Nachwuchsgruppe ,,Fungal Informatics" an der Universität Jena.
Dr. Grit Walther, Mitautorin des Beitrags und Co-Leiterin des NRZMyk am Leibniz-Institut für Naturstoff-Forschung und Infektionsbiologie - Hans-Knöll-Institut (Leibniz-HKI), fügt hinzu: ,,Die Studie macht deutlich, wie wichtig es ist, Pilzinfektionen und eventuelle Resistenzen schnell zu erkennen, um eine Übertragung auf andere Patientinnen und Patienten oder andere Einrichtungen zu verhindern. Sollten Kliniken nicht Über die Möglichkeit verfügen, das MLST selbst durchzuführen, können sich bei einem Ausbruchsverdacht an das NRZMyk wenden."
Exzellente Forschung im Verbund
Amelia E. Barber und Grit Walther mit Expertinnen und Experten des Paulinenkrankenhauses und diagnostischer Labore in Berlin. Die Arbeiten wurden von der Deutschen Forschungsgemeinschaft (DFG) und den Bundesministerien für Bildung und Forschung (BMBF) und für Gesundheit (BMG) gefördert.
Amelia Barber ist Mitglied des Exzellenzclusters ,,Balance of the Microverse" der Friedrich-Schiller-Universität. In diesem Forschungsverbund untersuchen Wissenschaftlerinnen und Wissenschaftler die komplexen Wechselwirkungen innerhalb mikrobieller Gemeinschaften sowie deren Auswirkungen auf die menschliche Gesundheit und die Umwelt.
Das vom Robert Koch-Institut und dem BMG berufene NRZMyk ist Ansprechpartner für Ärzte und Mikrobiologen aus ganz Deutschland bei Fragen zur Diagnostik und Behandlung invasiver Pilzinfektionen. Neben einer gezielten Beratung bietet das NRZMyk auch spezielle diagnostische Verfahren zum Nachweis von invasiven Pilzerkrankungen an.





